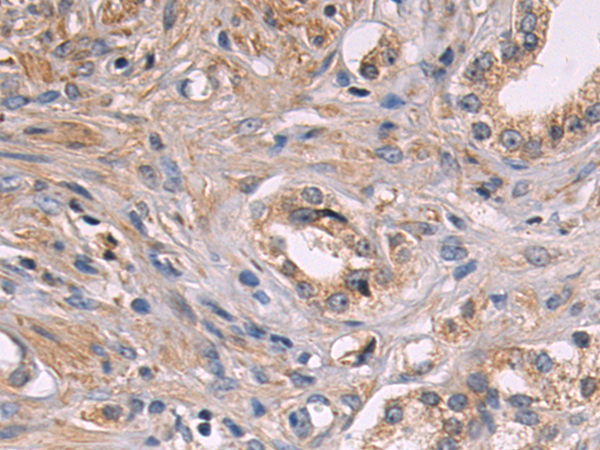

-
分类: 科研抗体货号: P07881别名: GFI2; p190-B; RhoGAP5; p190BRhoGAP应用: IHC反应种属: Human, Mouse
-
分类: 科研抗体货号: P07901别名: IP; IP1; IP2; FIP3; IPD2; NEMO; FIP-3; Fip3p; AMCBX1; ZC2HC9; IKK-gamma应用: IHC反应种属: Human, Mouse, Rat
-
分类: 科研抗体货号: P07880别名: RHOGAP; RHOGAP1; CDC42GAP; p50rhoGAP应用: IHC反应种属: Human, Mouse
-
分类: 科研抗体货号: P07900别名: FLK2; STK1; CD135; FLK-2应用: WB,IHC反应种属: Human, Mouse
-
分类: 科研抗体货号: P07879别名: ASAL应用: IHC反应种属: Human, Mouse, Rat
-
分类: 科研抗体货号: P07899别名: MLD应用: IHC反应种属: Human, Mouse
-
分类: 科研抗体货号: P07878别名: ARF1GAP; HRIHFB2281应用: WB,IHC反应种属: Human, Mouse
-
分类: 科研抗体货号: P07898别名:应用: IHC反应种属: Human, Mouse
-
分类: 科研抗体货号: P07877别名:应用: IHC反应种属: Human
-
分类: 科研抗体货号: P07897别名: ARP2应用: IHC反应种属: Human, Mouse, Rat

鄂公网安备42018502007531号
鄂公网安备42018502007531号

